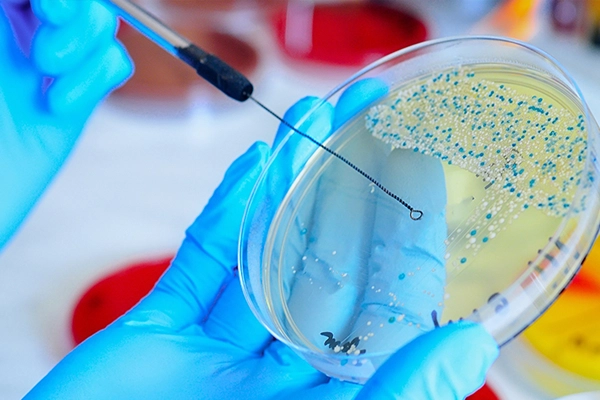

HAKKIMIZDA
Coregen Diagnostik
2015 yılından bu yana Türkiye’de faaliyet gösteren Coregen Diagnostik, ülkemizin önde gelen üniversitelerinde, tıp fakültelerinde, eğitim araştırma hastanelerinde ve özel hastanelerinde laboratuvar alanında başta olmak üzere çeşitli sektörlerde hizmet vermektedir. Sağlık, ar-ge ve endüstriyel sektörlerin temel ihtiyaçlarını karşılamak üzere kurulan şirketimiz, genç ve dinamik bir kadrosuyla Türkiye genelinde ve uluslararası alanda hizmet sunabilme yeteneğine sahiptir.